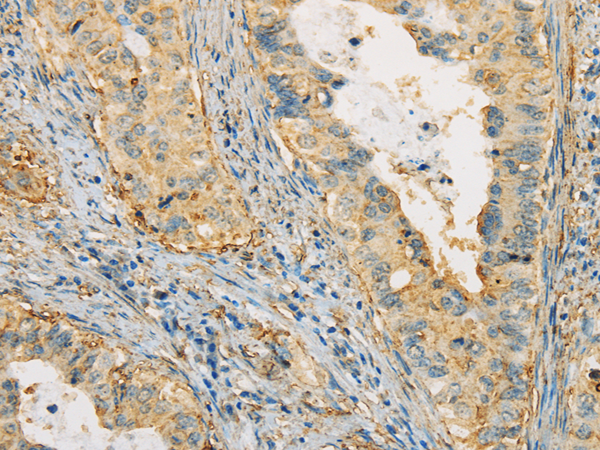

中文名稱: 兔抗APOA4多克隆抗體
|
Background: |
Apoliprotein (apo) A-IV gene contains 3 exons separated by two introns. A sequence polymorphism has been identified in the 3'UTR of the third exon. The primary translation product is a 396-residue preprotein which after proteolytic processing is secreted its primary site of synthesis, the intestine, in association with chylomicron particles. Although its precise function is not known, apo A-IV is a potent activator of lecithin-cholesterol acyltransferase in vitro. |
|
Applications: |
ELISA, WB, IHC |
|
Name of antibody: |
APOA4 |
|
Immunogen: |
Fusion protein of human APOA4 |
|
Full name: |
apolipoprotein A-IV |
|
SwissProt: |
P06727 |
|
ELISA Recommended dilution: |
2000-5000 |
|
IHC positive control: |
Human ovarian cancer and human cervical cancer |
|
IHC Recommend dilution: |
25-100 |
|
WB Predicted band size: |
45 kDa |
|
WB Positive control: |
Human serum |
|
WB Recommended dilution: |
200-1000 |

購物車
購物車 幫助
幫助
 021-54845833/15800441009
021-54845833/15800441009
